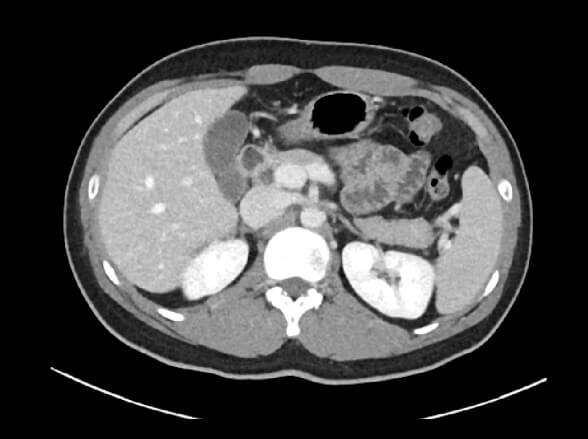
digital01

FDA 510(k) Clearance ·
CE Marked ·
MHRA Registered · MFDS Approved
All-in-one Medical Imaging Solution
for Analysis, 3D Modeling and Digital Twin

MEDIP Pro is a comprehensive software that processes medical images,
enabling image analysis, 3-dimensional construction, modeling, and design
with its automatic artificial intelligence (AI) segmentation technology at its core.
It supports files of various formats, such as DICOM, OBJ, STL, 3MF, and VTK.
All working files can be saved in MEDIP Pro file extension (.mip), which facilitates
an optimal working environment for specialized medical image processing.
All DICOMS
(X-ay, CT, MR)
NII
(Mask, HU)
3D Files
(OBJ, 3MF, VTK)
3D Visualization
(STL)
“The Future of
Medical Simulation Is Here!”
Introducing Medical Components Connector
for NVIDIA Omniverse
for NVIDIA Omniverse

X
NVIDIA OMNIVERSE is NVIDIA’s
cutting-edge-real-time 3D graphics platform
for facilitating digital twinning.
MEDICAL IP and NVIDIA collaborated to introduce
medical image-driven digital twinning
in the OMNIVERSE platform. The collaborative
innovation enables rapid prototyping of
medical
image-driven digital twins offering a state-of-the
realistic rendering, various physical simulations,
and multi-user connections.
cutting-edge-real-time 3D graphics platform
for facilitating digital twinning.
MEDICAL IP and NVIDIA collaborated to introduce
medical image-driven digital twinning
in the OMNIVERSE platform. The collaborative
innovation enables rapid prototyping of
medical
image-driven digital twins offering a state-of-the
realistic rendering, various physical simulations,
and multi-user connections.
“All You Can Do
with Medical Imaging.”
State-of-the-Art Technology for Segmentation
and Image Analysis
and Image Analysis
Digital Twin(AI)
MEDIP Pro is the optimal artificial intelligence
solution for generating digital twins from
medical
images.
With its
fast and accurate one-click
segmentation feature, MEDIP Pro automatically
segments and extracts all
anatomical components,
including organs and
lesions, from CT and MR
images. The digital twins of patients,
generated with MEDIP Pro, can be integrated withmedical metaverses, augmented and virtual reality, and precision
3D printing, making them applicable in
various fields such as clinical diagnosis, surgery,
education, and research.
AI segmentation

The AI segmentation function
automatically
segments
dozens of organs
and lesions with a single click.
automatically
segments
dozens of organs
and lesions with a single click.
CAD/CAM

The image segmented
by Drawcut and AI
segmentation is
designed with CAD/CAM
function
to be used in building
digital twin
and metaverse.
by Drawcut and AI
segmentation is
designed with CAD/CAM
function
to be used in building
digital twin
and metaverse.
Converting 2D image to 3D Model
MEDIP Pro enables the rapid transformation of 2D flat medical images, such as CT and MRI scans, into detailed and instant 3D visualized models.
Fast and Precise AI Segmentation *over 100 organs
MEDIP Pro provides a single-click automated segmentation capability that accurately segments each organ region from 3D-implemented medical images.
Customizable Deep-Learning Engine
Users can request segmentation customization and utilize customized deep-learning engine modules with masks obtained from regional segmentation.
Integrated with Advanced Technologies
MEDIP Pro enables image enhancement, texture analysis, and integration with various technologies and industries such as VR, AR, and 3D printing.
Brain

Chest

Abdomen

Bone & Muscles

Converting 2D image to 3D Model
MEDIP Pro enables the rapid transformation of 2D flat medical images, such as CT and MRI scans, into detailed and instant 3D visualized models.
Fast and Precise AI Segmentation *over 100 organs
MEDIP Pro provides a single-click automated segmentation capability that accurately segments each organ region from 3D-implemented medical images.
Customizable Deep-Learning Engine
Users can request segmentation customization and utilize customized deep-learning engine modules with masks obtained from regional segmentation.
Integrated with Advanced Technologies
MEDIP Pro enables image enhancement, texture analysis, and integration with various technologies and industries such as VR, AR, and 3D printing.
Watch the video and discover the outstanding
features of MEDIP Pro!
features of MEDIP Pro!
Explore The Advanced Features
of MEDIP Pro





